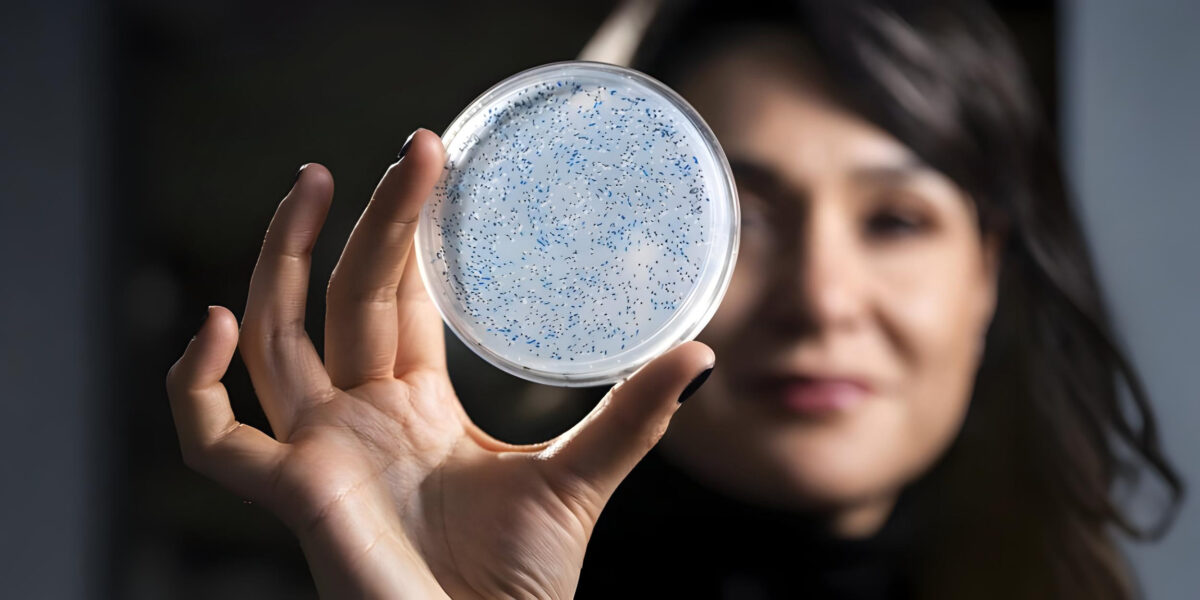
Betül Kaçar zeigt in ihrem Labor Proben aus einem Experiment

3,2 Mrd. Jahre alt und wieder aktiv: Enzym aus der Urzeit kehrt zurück
Ein uraltes Enzym wurde im Labor reaktiviert. Die Ergebnisse helfen, frühes Leben auf der Erde besser zu verstehen.
Betül Kaçar zeigt in ihrem Labor Proben aus einem Experiment, bei dem ein rekonstruierter Vorläufer der Nitrogenase untersucht wird – ein Enzym, das bereits vor rund 3,2 Mrd. Jahren am Stoffwechsel früher Mikroben beteiligt war.
Foto: Jeff Miller/UW–Madison
Wie funktionierte Leben, als die Erde noch keinen Sauerstoff kannte? Eine aktuelle Studie liefert darauf eine konkrete, experimentell überprüfbare Antwort. Forschende der University of Wisconsin–Madison haben ein uraltes Enzym rekonstruiert, das bereits vor rund 3,2 Mrd. Jahren aktiv war – und es in heutigen Mikroben wieder zum Arbeiten gebracht. Das Ziel: besser verstehen, wie frühes Leben an einen der wichtigsten Nährstoffe kam und welche Spuren es dabei im Gestein hinterließ.
Inhaltsverzeichnis
Ein Schlüsselprozess für alles Leben
Im Mittelpunkt steht die Nitrogenase. Dieses Enzym ermöglicht es Mikroorganismen, Stickstoff aus der Luft in eine Form umzuwandeln, die Zellen nutzen können. Ohne diesen Prozess gäbe es weder Pflanzen noch Tiere – auch heute noch hängt fast alles Leben indirekt davon ab.
„Wir haben ein Enzym ausgewählt, das den Ton für das Leben auf diesem Planeten angibt, und dann seine Geschichte untersucht“, sagt Betül Kaçar. „Ohne Nitrogenase gäbe es kein Leben, wie wir es kennen.“
Fossilien reichen nicht aus
Für die Frühzeit der Erde fehlen klassische Fossilien. Forschende stützen sich deshalb auf chemische Spuren im Gestein, sogenannte Isotopensignaturen. Beim biologischen Fixieren von Stickstoff entsteht ein charakteristisches Verhältnis bestimmter Stickstoffisotope, das sich über Milliarden Jahre in Sedimenten erhalten kann.
Bisher basierten viele Deutungen auf einer Annahme: dass alte Enzyme dieselben Isotopensignaturen erzeugten wie heutige. Genau diese Annahme hat das Team nun experimentell überprüft.
Synthetische Biologie statt Zeitmaschine
Die Forschenden nutzten Methoden der synthetischen Biologie. Sie rekonstruierten mithilfe evolutionsbiologischer Modelle mehrere Vorläufer der Nitrogenase, die zeitlich bis über 2 Mrd. Jahre zurückreichen. Diese Gene synthetisierten sie künstlich und bauten sie in das Bakterium Azotobacter vinelandii ein.
So entstanden lebende Mikroben, die nicht mit moderner, sondern mit „archaischer“ Nitrogenase arbeiteten. Unter kontrollierten Laborbedingungen konnten die Forschenden messen, welche Isotopensignaturen diese alten Enzymvarianten erzeugen.
Das Ergebnis überrascht nicht – und ist gerade deshalb wichtig
Die zentrale Beobachtung: Die wiederbelebten Enzyme erzeugen praktisch dieselben Stickstoff-Isotopensignaturen wie moderne Nitrogenasen. Zwar unterscheiden sich ihre DNA-Sequenzen deutlich, doch der chemische Mechanismus blieb stabil.
„Die Signaturen, die wir in der fernen Vergangenheit sehen, sind dieselben, die wir heute sehen“, sagt Holly Rucker. Das bedeutet: Die geochemischen Archive der Erde lassen sich tatsächlich zuverlässig lesen – zumindest für diesen zentralen Stoffwechselprozess.
Blick in eine sauerstofffreie Welt
Die Ergebnisse erlauben auch Rückschlüsse auf die Umweltbedingungen der frühen Erde. Vor dem sogenannten Großen Oxidationsereignis enthielt die Atmosphäre kaum Sauerstoff, dafür mehr Methan und Kohlendioxid. Leben existierte fast ausschließlich in Form anaerober Mikroben.
Dass die Nitrogenase unter diesen Bedingungen bereits funktionierte und ihre Isotopensignatur über Milliarden Jahre stabil blieb, spricht für eine sehr frühe Etablierung dieses Stoffwechselwegs – möglicherweise sogar vor den ältesten bisher bekannten Gesteinen.
Bedeutung für die Astrobiologie
Die Studie ist Teil des NASA-finanzierten Forschungsverbunds MUSE, der von Kaçar geleitet wird. Ziel ist es, Biosignaturen zu identifizieren, die sich auch auf anderen Planeten nachweisen lassen. Stickstoff-Isotope gelten nun als besonders robuste Marker.
„Als Astrobiologen sind wir darauf angewiesen, unseren Planeten zu verstehen, um das Leben im Universum zu verstehen“, sagt Kaçar. „Die Suche nach Leben beginnt hier bei uns zu Hause.“
Ein Beitrag von:














